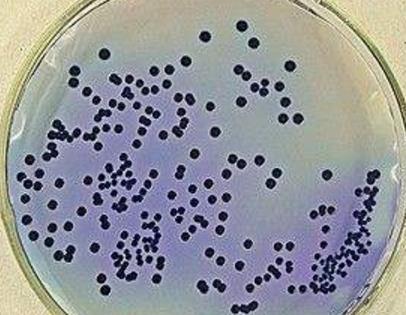

资讯
疾病资讯
-
来源:justone 2017年12月20日
近日,一个跑运输的女孩成为网红,因为运输行业很辛苦,很少有女孩会去从事运输这一行业,但是这个90后女孩走不寻常道路她与父亲跑运输,据报道称,常年跑运输的大车司
-
来源:justone 2017年12月20日
近日,莎普爱思股票跌停,原起莎普爱思12月2日被“丁香医生”质疑涉嫌虚假广告宣传,随后莎普爱思在12月6日被国家食药监总局要求尽快启动临床有效性试验;12月7日,股
-
来源:justone 2017年12月20日
谁是李艺彤?很多人还莫名其妙,小编就给大家介绍一下,李艺彤是SNH48组合的成员之一,而SNH48是中国本土化大型女子偶像团体,取“上海”的“ShangHai”的拼音缩写从而
-
来源:justone 2017年12月20日
小编关注何洁是从2005年《超级女声》开始,她给人的印象一直是一个会唱歌和努力的女孩,但是就在事业最红的时候遇到前夫赫子铭。但是婚后不到几年时间,2016年宣布和
-
来源:justone 2017年12月20日
近日,在贝嫂的社交媒体状态中,我们看见了贝嫂与四个孩子的罕见合影,贝嫂并配文称:“布鲁克林回家了,我非常非常非常高兴。”在照片中我们看见最大的孩子大布已经成
-
来源:sunny 2017年12月19日
尿道炎和膀胱炎同属于泌尿系统疾病,二者有很多相似之处,但同时又有本质的区别,那么,究竟怎么鉴别自己患上的是尿道炎还是膀胱炎呢?下面就来和大家一起探讨一下两者
-
来源:tmsdzafd 2017年12月19日
佛罗里达大学的研究人员发现了一种罕见的突变,导致与尿路感染(UITs)相关的细菌中的喹诺酮类抗生素左氧氟沙星产生耐药性。该研究从180名大学女性首次接受尿路感染
-
来源:tmsdzafd 2017年12月22日
生殖器支原体(包含解脲支原体,人型支原体和生殖支原体)是一组通常在性活跃的女性和男性中发现的微生物。它们缺乏细胞壁,并且倾向于粘附于粘膜表面,有时甚至具有进
-
来源:tmsdzafd 2017年12月19日
尽管一些物种可以作为共生微生物菌群存在于女性生殖道中,但是解脲支原体,人型支原体和生殖支原体已经显示引起几种不同的临床实体。这些可能从细菌性阴道炎和宫颈
-
来源:tmsdzafd 2017年12月19日
“支原体”用于指任何属于Mollicutes类的微生物。其中,生殖器支原体主要是通过性传播(虽然也可能传染给子宫内或出生时的婴儿)。已知的自由生命微生物中它们具有最
最热资讯
最新资讯
-
对于处于更年期的女性来说,睡眠是一项需要改善的问题,...
-
失眠是大多数人都会有的一种经历,因为它是一种很常见的...
-
咖啡使我们非常熟悉的一种饮品,对于白领们来说喝咖啡是...
-
许多女性朋友都有这么一个烦恼,为什么我每天都运动可还...
-
年龄是许多女人很在意的,几乎所有的女人都会介意自己的...
-
有人会说中年女人非常有魅力,又有的人觉得中年女人人老...
-
熬夜在许多人眼里,并不是一件可怕的事情,反而是一件很...
-
从现代医学角度讲,引起老寒腿的原因是有许多的。很多人...
-
在中老年人中肥胖也是很常见的,肥胖经常会给我们的生活...
-
在我们的生活中有的人他并不胖,有的人喝水也会长胖,而...